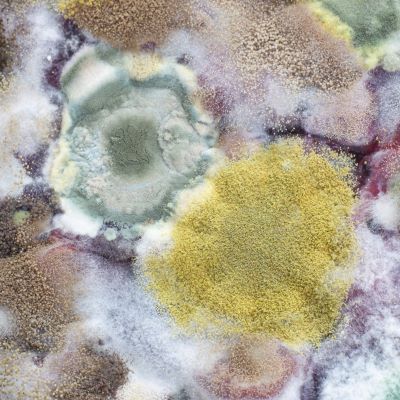
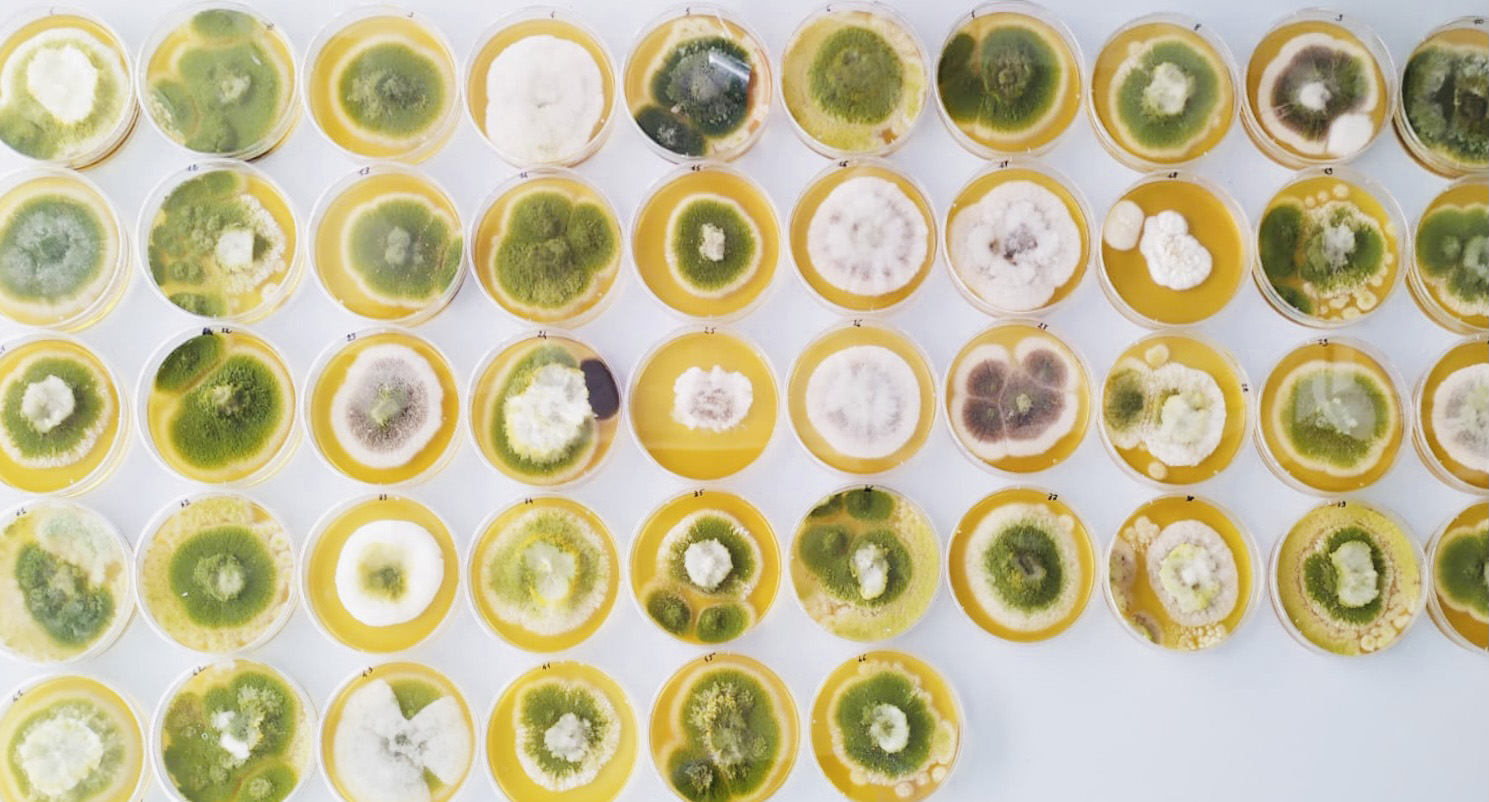

The Magan Centre of Applied Mycology (MCAM) aims to become an interdisciplinary world-leading centre of excellence dedicated to pioneering mycological research that harnesses the transformative potential of fungi in fostering a sustainable, green economy.
The centre is named in memory of Professor Naresh Magan, whose profound research impact and his mentorship serves as the bedrock upon which the MCAM is founded. It is with this rich heritage that Cranfield University embarks on a journey to raise MCAM into a leading research hub in the United Kingdom, poised to address critical aspects of the United Nations Sustainable Development Goals (UN SDGs) and facilitate our transition to a net-zero future through unexplored capabilities of fungi.
In anticipation of our ambitious objectives, MCAM envisions the recruitment of over 25 new members to our team by 2027/2028, spanning a broad spectrum of expertise. Through this effort, we seek to nurture the next generation of mycology researchers and industry practitioners, poised to lead the UK transition to a green economy empowered by fungi and achieving the global Net Zero targets.
To kick-start the MCAM has secured £7.2 million investment from Research England including £5.8 million to support staff recruitment and £1.4 million for new sustainable and cutting-edge equipment complementing existing University ones.